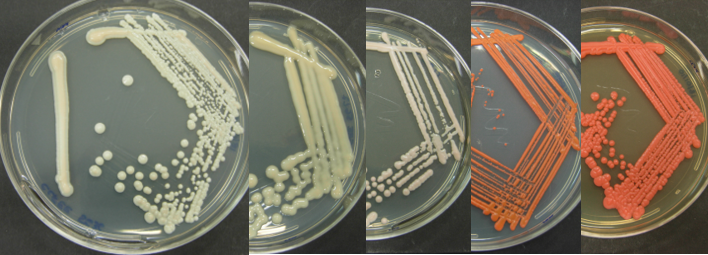
foto_26b.png

UNIVERSITY OF PERUGIA
DSA3 - Department of Agricultural, Food and Environmental Sciences
Food Technology and Biotechnology Research Unit
DBVPG of the Department of Agricultural, Food, and Environmental Sciences
Thanks to an intra-University conventional agreement, the CERB collaborates with the DBVPG Industrial Yeast Collection, of which Prof. Pietro Buzzini (Full Professor, disciplinary sector AGR/16) is the scientific coordinator.
The DBVPG Industrial Yeast Collection of the Department of Agricultural, Food and Environmental Sciences (DSA3) of the University of Perugia is a biological resources centre affiliated with the following international organisations:
- ECCO (European Culture Collection Organisation)
- WFCC (World Federation of Culture Collections).
The DBVPG Collection specialises in the study and ex-situ conservation of yeasts, and its main objectives are the acquisition, classification, conservation, characterisation and distribution of yeast strains and yeast-like organisms.
The DBVPG Collection conserves over 7,000 strains that represent a large percentage of the yeast biodiversity described to date and that have been isolated from both industrial environments (e.g. alcoholic fermentation industry) and natural environments (e.g. tropical forests, glacial ecosystems). Globally, it ranks among the top 5 collections in the world for the number of yeast strains conserved and since 1995 it has been an International Depositary Authority (IDA) according to the Budapest Treaty (currently there are 48 IDAs in the world and only 3 are in Italy) and as such can accept the deposit of yeast strains or yeast-like organisms, non-pathogenic, for patent purposes.
The DBVPG Collection is also a center able to provide consultancy services on the scientific and biotechnological aspects of yeasts. It offers a range of services, including identification, storage of yeast strains or yeast-like organisms, screening for biotechnological properties, as well as specific training courses on the study and use of yeasts.
Since 2019, the DBVPG Collection has been a founding member of the Joint Research Unit MIRRI-IT, which represents the Italian node of the pan-European research infrastructure for microbial resources MIRRI (Microbial Resource Research Infrastructure, www.mirri.org).
For more information: www.dbvpg.unipg.it.

UNIVERSITY OF UDINE
DI4A - Dipartimento Di Scienze Agroalimentari, Ambientali e Animali
Thanks to an inter-University agreement, CERB avails itself of the collaboration of Dr. Stefano Buiatti (Researcher, disciplinary sector AGR/15).
ASSOBIRRA
The Association of Brewers and Maltsters was founded in 1947 and brings together the major companies that produce and market beer in Italy, carrying out institutional, promotional and technological development functions for the beer sector.
It is the body responsible for monitoring beer consumption in Italy, carrying out activities aimed at educating people about responsible consumption of beer, as an alcoholic beverage, and developing the culture of the product.
In addition to Confindustria, it also adheres to Federalimentare and is part of BoE (The Brewers of Europe), Euromalt (Comité de Travail des Malteries) and the EBC (European Brewery Convention).

